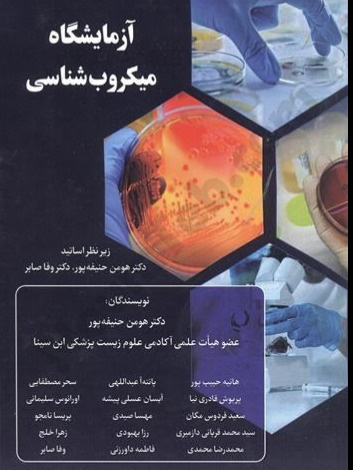

آزمایشگاه میکروبشناسی
مشخصات
نوع چاپتک رنگ
مولفهومن حنيفهپور
سال چاپ1403
تعداد صفحات354
ناشرتیمورزاده نوین
۷ روز ضمانت بازگشت کالا
ضمانت اصل بودن کالا
تیمورزاده نوین
این محصول موجود است.
جهت نمایش قیمت و خرید، سایز محصول خود را انتخاب کنید
جهت نمایش قیمت و خرید، سایز محصول خود را انتخاب کنید
محصولات مشابه
معرفی محصول
مشخصات
نوع چاپتک رنگ
مولفهومن حنيفهپور
سال چاپ1403
تعداد صفحات354
ناشرتیمورزاده نوین
قطعوزیری
شابک978-622-5267-75-6

دیدگاهها